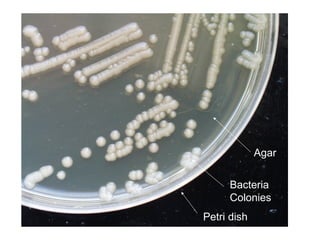
Agar


      Bacteria
      Colonies
Petri dish

This chapter discusses the classification of organisms into a taxonomic system. It describes how Carolus Linnaeus developed the binomial nomenclature system of scientific naming that is still used today. The chapter also explains how modern evolutionary classification uses cladograms and molecular evidence like DNA comparisons to group organisms based on lines of evolutionary descent rather than just physical similarities. Finally, it outlines the three domain system of classification, separating all living things into the domains of Archaea, Bacteria, and Eukarya.